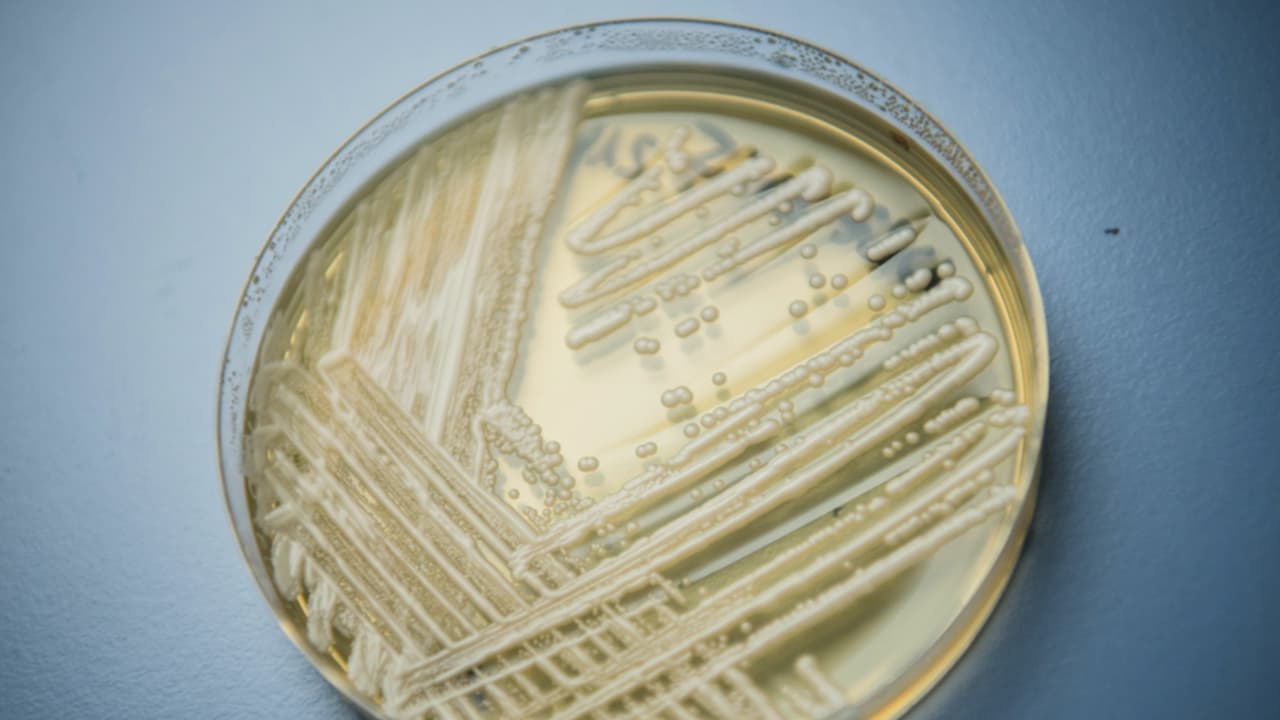

Autoridades de salud en EEUU alertan del surgimiento de un súper hongo resistente a medicamentos
Se llama 'Candida auris' y, según expertos en enfermedades infecciosas, podría ser mortalmente mayor en personas con sistema inmunológico débil. Hasta finales de febrero, los Centros para la Prevención y Control de Enfermedades (CDC) reportaron cerca de 600 casos a nivel nacional, de los cuales 309 se detectaron en Nueva York, 144 en Illinois y 104 en Nueva Jersey.
Por:Peggy Carranza
Publicado el 9 abr 19 - 11:55 PM EDT.